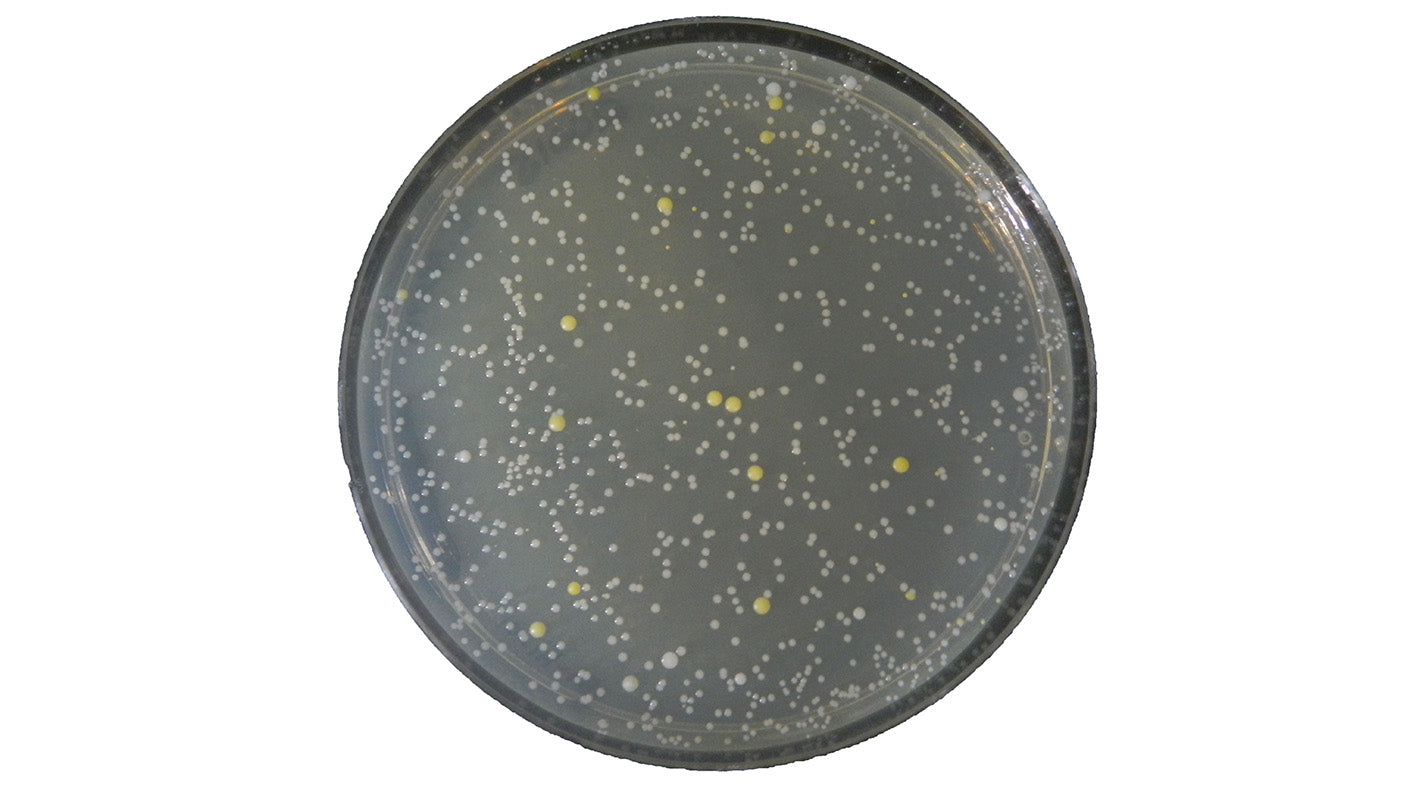

The Staph & Cory Chronicles: Tales from the Underarm Underground
20 Posts in Review: Your Complete Journey to Freshness with Natural Deodorant
Natural Deodorant Transition Period: Myth or Marketing?
How to Switch to Natural Deodorant—No “Detox” Required
Why Most Natural Deodorants Fail—and What Makes Ours Different
What Does “Clinically Tested” Really Mean in Natural Deodorant?

The Humiliation That Started It All: My 8‑Year Quest to Build BioShield™

The Future of Natural Deodorant Innovation: A Comprehensive Scientific Analysis

The Science of Sweat: How Natural Deodorants Keep You Fresh All Day

The Bacterial Bachelor: Sweat, Science & Natural Deodorant Showdown

Tales from the Pit: A Bacterial Guide to Green Chemistry

Armpit Detox Decoded: A Bacterial Myth‑Busting Special Report

Armpit Detox Decoded: What Really Happens When You Switch to Natural Deodorant

Why Aluminum-Free Deodorants Are the Future (And How They Actually Work)

The Corporate Wellness Crisis: Can Stress‑Free Living Eradicate Body Odor?

The Pit Stop Chronicles: A Microbial Tour Through Deodorant History

BioShield™ Breakdown: Why Zaffré’s Deodorant Actually Works

The Hidden World of Armpit Bacteria: What’s Really Living in Your Pits?
The Big Disruption: Zaffré vs. the Armpit Underground

Cory’s Corner: How One Bacteria Plans to Outlive Deodorant Tech

Staph’s Log: When the Sweat Stopped, So Did the Funk
Showing 20/21